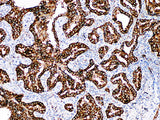
Napsin A Monoclonal Antibody Stored at 2~8°C

Napsin A Monoclonal Antibody Stored at 2~8°C
SKU: PA6695-1.5
To better serve you, we would like to discuss your specific requirement.
Please Contact Us for a quote.
Napsin A Monoclonal Antibody Stored at 2~8°C
Product Details
| Host | Mouse |
| Reactivity | Human |
| Applications | IHC-P |
| Synonyms | Napsin A |
| Cellular Localization | Cytoplasm |
| Tissue Specificity | Lung adenocarcinoma |
| Storage | The RTU should be stored at 2~8°C protecting from light (Do not freeze),Valid for 12 months. |
| Shipping | Ice bag |
Background
Napsin is a kind of gastric enzyme like aspartate protease. There are two related Napsin: Napsin A and Napsin B. Napsin A is a single chain protein with molecular weight close to 38 kDa.It is highly expressed in human lung and kidney, but low in spleen. Napsin A is expressed lung type II epithelium and lung adenocarcinoma. The expression sensitivity of Napsin A in lung adenocarcinoma is significantly higher than SP-A and SP-B, and it has very high specificity. In some cases of poorly differentiated lung adenocarcinoma without TTF-1, but Napsin A is expressed.Napsin A Monoclonal is recommended to be used in combination with TTF-1 for the differentiation of primary lung adenocarcinoma and other tissue-derived adenocarcinoma.